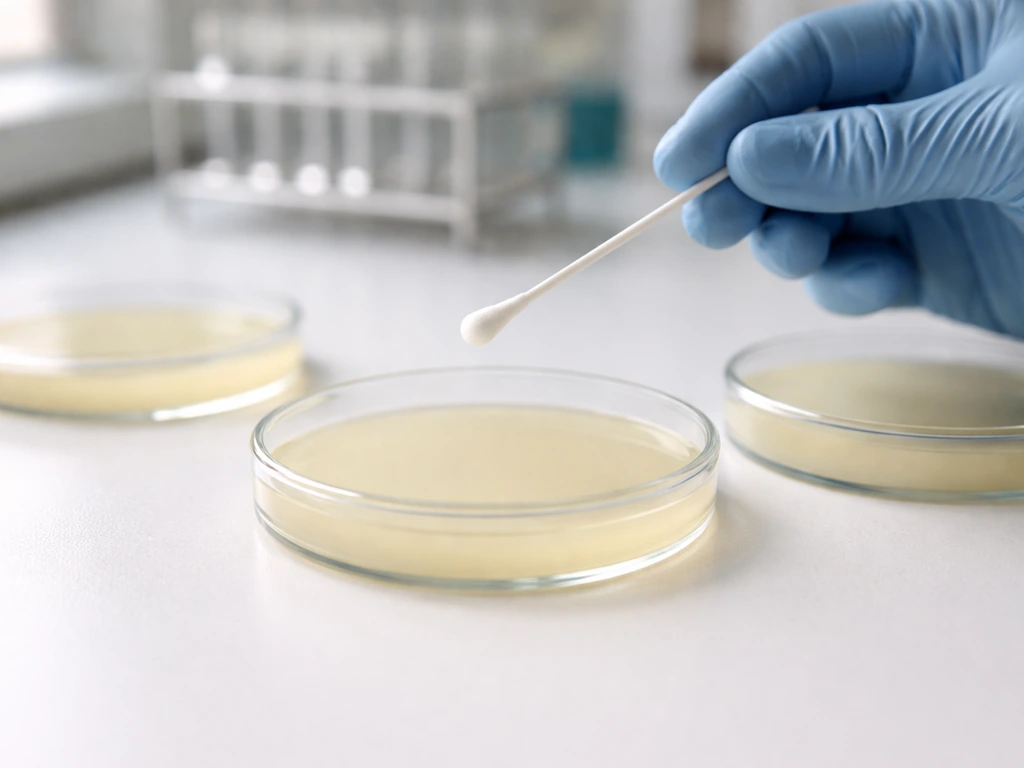
Laboratory bench with a minimal MSA agar plate set showing no colonies and no color change
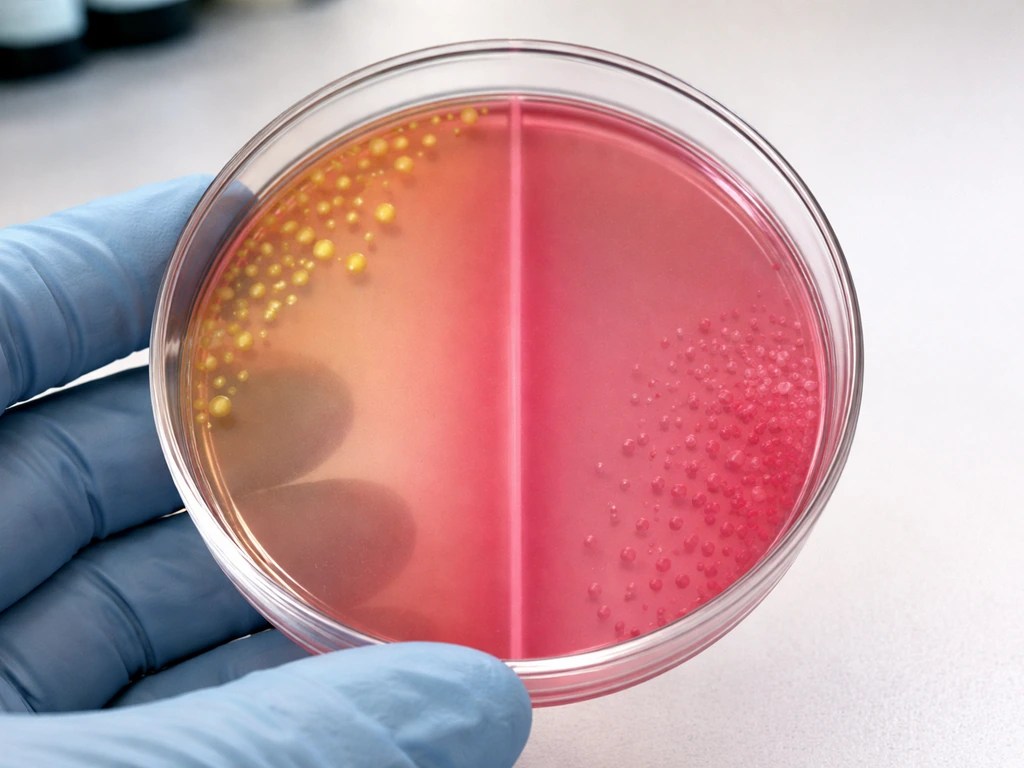
Close-up of an agar culture plate showing two separated regions with growth/no-growth and yellow vs pink colonies.
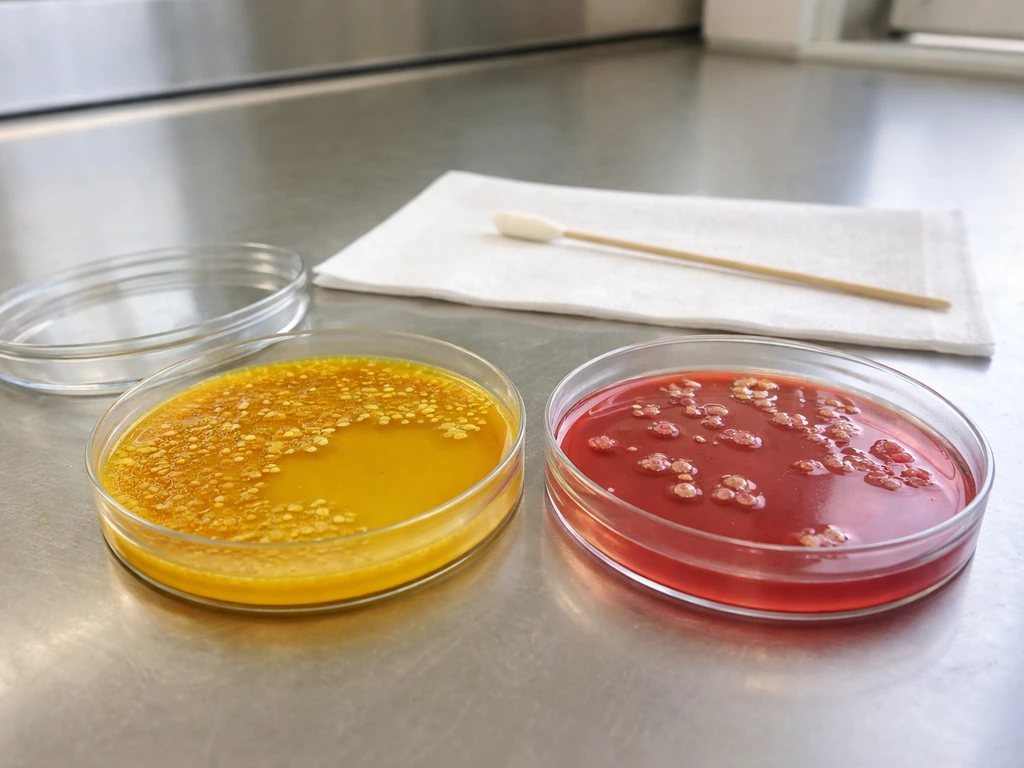
MSA agar plates on a lab bench, one showing typical yellow-zone growth beside an unknown sample plate.

No, E. coli does not grow on mannitol salt agar under standard conditions. It is inhibited by the 7.5% sodium chloride content of the medium. This is by design: MSA is formulated specifically to block most Gram-negative bacteria, including E. coli, while selecting for salt-tolerant organisms like staphylococci. If you are testing an unknown sample and see no growth where you expected E. coli, that result is exactly correct.
Does E. coli Grow on Mannitol Salt Agar? Growth Guide
What MSA is actually designed to do
Mannitol salt agar works through two mechanisms working together. First, the high sodium chloride concentration (7.5%) acts as the selective agent: it partially or completely inhibits most bacteria, allowing only halotolerant (salt-tolerant) organisms to establish colonies. Second, the medium contains 1% mannitol and phenol red (at 0.025 g/L) as a differential indicator. When an organism ferments mannitol, it produces acidic end products that shift the pH downward, turning the phenol red indicator from its normal red-pink color to yellow. The final pH of the prepared medium sits at 7.4 ± 0.2 at 25°C, so any drop toward acidity is clearly visible as a color change.
The practical result is a medium that both selects (only salt-tolerant organisms survive) and differentiates (those that ferment mannitol show a color change, those that don't stay pink or red). That combination is why MSA is the standard presumptive medium for staphylococci in food microbiology workflows, including FDA BAM method M97.
The direct answer on E. coli and MSA
E. coli is inhibited on MSA. Quality control data from multiple manufacturers confirm this consistently. HiMedia lists Escherichia coli ATCC 8739 as showing zero recovery on their M118 MSA formulation. Bio-Rad's QC insert for Chapman Mannitol Salt Agar reports complete inhibition of E. coli ATCC 25922 after 24 to 48 hours at 37°C. The ASM image gallery for MSA shows the same result visually: no growth at all in the E. coli streak.
Why does this happen? E. coli is a Gram-negative enteric bacterium. It is not salt-tolerant at the 7.5% NaCl concentration MSA contains. That salt level creates osmotic stress that prevents the organism from growing. If you want to understand where E. coli grows in terms of its preferred environments and substrates, MSA is definitively not one of them. The inhibition is not partial or strain-dependent under standard conditions: it is complete.
Which bacteria grow on MSA and which don't
Here is the species-by-species breakdown for the organisms most commonly tested against MSA. This covers every organism you are likely to encounter when using this medium.
| Organism | Grows on MSA? | Mannitol Fermentation? | Expected Appearance |
|---|---|---|---|
| Staphylococcus aureus | Yes | Yes | Yellow or white colonies with yellow zone in medium |
| Staphylococcus epidermidis | Yes | No | Small colonies; medium stays pink/red |
| Escherichia coli | No (inhibited) | N/A | No growth |
| Pseudomonas aeruginosa | No (inhibited) | N/A | No growth |
| Streptococcus pneumoniae | No (inhibited) | N/A | No growth |
| Streptococcus pyogenes | No (inhibited) | N/A | No growth |
| Enterococcus faecalis | Variable (partial growth possible) | Weak/variable | Sparse growth; minimal color change |
| Bacillus cereus | Variable (partial halotolerance) | Variable | May show sparse growth; check carefully |
| Bacillus subtilis | Variable (partial halotolerance) | Variable | May show some growth at lower inocula |
| Enterobacter aerogenes | No (inhibited) | N/A | No growth |
The two Staphylococcus species are the core comparison on MSA. S. aureus is the textbook positive: it grows well and ferments mannitol, producing visible yellowing. S. epidermidis is the textbook non-fermenter: it tolerates the salt and grows, but it does not ferment mannitol, so the medium stays its normal pink-red color. This is the key differential the medium is designed to show. Understanding what bacteria can grow on cetrimide agar helps put selective media like MSA in broader context, since both media rely on chemical inhibitors to screen for specific genera.
Enterococcus faecalis occupies a gray zone. Enterococci are Gram-positive and have some salt tolerance, so limited or partial growth is possible on MSA. However, they are not the target organism and results can be inconsistent. If you are seeing unexpected sparse growth on a plate where you expected no staphylococci, enterococci or bacilli may be the explanation.
How Gram status, salt tolerance, and mannitol fermentation interact
The most useful mental model here: MSA filters by salt tolerance first, and differentiates by mannitol fermentation second. Gram-negative bacteria as a group are generally not halotolerant at 7.5% NaCl. That rules out E. coli, Pseudomonas aeruginosa, and Enterobacter aerogenes at the first hurdle. None of them make it past the salt barrier, regardless of whether they could ferment mannitol in a less inhibitory environment.
Gram-positive bacteria are a more mixed picture. Staphylococci are the specifically targeted group because they evolved in environments (skin, mucous membranes) that can be high-salt. Streptococci and enterococci are also Gram-positive, but most are not adapted to the 7.5% NaCl level MSA uses. Streptococcus pneumoniae and Streptococcus pyogenes are inhibited. Enterococcus faecalis sits closer to the tolerance threshold, which is why you can sometimes see minimal growth. Bacillus species have variable salt responses depending on strain; some can tolerate moderate salt levels but MSA's concentration is at the high end for most.
This also explains why MSA results can look different from what you might expect when testing organisms across different growth conditions. For example, if you are curious about whether E. coli can grow in an acidic environment, you know it can handle pH stress to a degree, but salt stress at MSA concentrations is a separate and more complete barrier.
Reading your MSA plate correctly
Yellow vs pink/red: what the color actually tells you
The most important interpretation rule: color change must occur in the medium around or under the colonies, not just in the colony itself. Acid from mannitol fermentation diffuses into the surrounding agar, turning the phenol red indicator yellow. A yellow zone in the medium around colonies confirms mannitol fermentation. If colonies are present but the medium stays its normal salmon-pink-red color, the organism grew but did not ferment mannitol. Do not call a result positive for mannitol fermentation based on colony color alone.
HiMedia's QC standard for S. aureus ATCC 6538 describes the expected result as yellow or white colonies surrounded by a yellow zone in the medium after 18 to 72 hours at 35 to 37°C. That yellow zone in the medium is the signal you are looking for. This same phenol-red-based differentiation approach appears in several selective agars: if you have worked with what bacteria grow on bile esculin agar, you are already familiar with the concept of medium color change as a differential marker.
Timing matters more than you think
Read plates after 24 to 48 hours of aerobic incubation at 35 to 37°C. HiMedia notes that a few S. aureus strains can show delayed mannitol fermentation, meaning the yellowing may be weak or appear only after extended incubation. If you read a plate at 24 hours and see pink medium around S. aureus-looking colonies, do not immediately conclude there is no fermentation. Allow up to 72 hours before making a final call, especially with atypical or clinical isolates.
Common misreads to avoid
- Yellow colony color without a yellow zone in the medium is not fermentation: some pigmented organisms produce yellow colonies that have nothing to do with mannitol metabolism.
- Partial yellow spreading from a heavy inoculum can be a handling artifact: use a light to moderate inoculum and streak for isolation.
- Fading or uneven plate color before inoculation may indicate a compromised medium: check plates before use.
- Sparse growth that is not staphylococcal may be enterococci, bacilli, or even yeast contamination rather than a Gram-negative breakthrough.
Practical troubleshooting if you're testing an unknown sample right now
Start with known controls on every MSA run. Your positive control should be S. aureus ATCC 25923 (Bio-Rad) or ATCC 6538 (HiMedia): expect luxuriant growth with yellow zones. Your negative control for inhibition should be E. coli ATCC 25922 or ATCC 8739: expect zero growth. If either control fails, the medium or the incubation conditions are the problem, not your unknown sample.
If you are using MSA to screen a food sample or environmental swab for staphylococci, here are the practical steps to follow:
- Allow MSA plates to warm to room temperature and dry the surface before inoculating. Hardy Diagnostics' IFU specifically instructs this step to avoid condensation interfering with colony morphology.
- Streak or spread your sample and incubate aerobically at 35 to 37°C for 24 to 48 hours. Read again at 72 hours if results are ambiguous.
- Record growth and medium color separately. Note whether colonies are present and whether the medium changed from red-pink to yellow.
- If you see unexpected growth (especially from a sample expected to have only Gram-negatives), subcultue suspect colonies to a less selective medium like tryptic soy agar for confirmation. HiMedia specifically recommends subculturing to a less inhibitory medium if you suspect the salt level may be suppressing your target.
- Confirm presumptive S. aureus colonies with coagulase testing. MSA is presumptive, not confirmatory.
- If you are unsure whether MSA is the right general-purpose plate for your unknown, remember that E. coli will grow on a TSA plate without restriction, which makes TSA a useful parallel control to confirm your sample contains viable organisms.
One situation worth flagging: if you plate a sample on MSA and see growth where E. coli or other Gram-negatives were expected to be inhibited, do not automatically assume a contamination event. First rule out medium problems: check the lot number, preparation records, and whether the salt concentration was correct. Improperly prepared MSA (for example, if insufficient NaCl was incorporated during autoclave preparation) will fail to inhibit Gram-negatives and will give you misleading results.
If you are working with an environmental or food safety context and need to understand E. coli behavior more broadly, knowing what temperature E. coli grows best at is useful background: it grows optimally between 35 and 37°C, the same range used for MSA incubation, so temperature is not why it fails on this medium. The salt is the sole inhibitor.
A note on newer or unusual organisms in your sample
Most standard microbiology education and QC documentation focuses on the organisms above, but real-world samples can contain less common bacteria. MSA's selectivity is based on salt tolerance, so any organism with significant halotolerance may show partial growth. Some environmental isolates of Bacillus or halophilic organisms from food processing environments can breach the 7.5% NaCl barrier. This is very different from the typical clinical or food safety scenario but worth knowing if you are working with marine or brined food samples.
For comparison, it is useful to understand organisms that occupy very different environmental niches. How Ideonella sakaiensis grows is a good example of a highly specialized organism with narrow environmental requirements, illustrating just how differently bacteria adapt to their surroundings, which is precisely why selective media like MSA work as well as they do against most common pathogens.
The bottom line on E. coli and MSA
E. coli does not grow on mannitol salt agar. Its inhibition is complete under standard conditions and is confirmed by multiple manufacturers' QC data using reference strains. MSA is designed to grow staphylococci, differentiate S. aureus (yellow zones) from S. epidermidis (no color change), and block virtually everything else including all common Gram-negative enteric bacteria. If you are running a plate today and see no growth where E. coli was expected, that is the correct result. If you see unexpected growth, check your controls and medium preparation before drawing conclusions about your sample.
FAQ
Can E. coli grow on mannitol salt agar if I incubate it for longer than 48 hours?
If you incubate longer or at slightly different temperatures, E. coli generally still will not recover on MSA because the 7.5% NaCl causes osmotic stress strong enough to block growth. However, weak or sporadic colonies (rare) usually mean the medium was not prepared correctly (for example, NaCl content too low, wrong agar base, or a label mix-up). That is why QC controls are essential on every run.
If I see colonies, how do I tell whether the mannitol fermentation result is valid on MSA?
Use MSA only for what it is designed to do. A colony with no surrounding yellow halo (the agar around the colony stays salmon-red) should not be interpreted as mannitol fermentation, even if the colony itself looks different. For confirmatory interpretation, you need both growth and a yellow zone in the agar around or under colonies.
What could explain growth on MSA when I expected E. coli to be inhibited?
Yes, unexpected growth with bacteria other than staphylococci can happen, but it does not mean E. coli is passing the salt barrier. Most likely explanations are medium issues (incorrect NaCl concentration, swapped plates, improper mixing during preparation) or the presence of salt-tolerant non-target organisms (for example, some halotolerant Bacillus). Always verify with your negative control.
If E. coli is not recovered on MSA, can I conclude my sample has no E. coli?
Do not treat MSA as a definitive ID plate for E. coli. The correct conclusion from a standard MSA workflow is simply that E. coli should be inhibited, so no colonies is the expected outcome. If you suspect E. coli in the original sample, use additional confirmatory tests (for example, targeted identification methods) rather than relying on MSA absence or presence alone.
How should I interpret a weak or partial yellow color change around colonies?
Sometimes agar around colonies can yellow due to weak acid diffusion, so you should compare the zone pattern against nearby uninoculated areas on the same plate. A true mannitol fermentation signal is a consistent yellowing of the agar around colonies, not just color variations limited to the colony surface.
Is MSA a good medium to test for or detect E. coli in environmental or food samples?
If your goal is to test E. coli specifically, you should not use MSA as a screening endpoint. MSA is selective for salt-tolerant organisms and differential for mannitol fermentation, so the negative result is expected but not informative enough for detection. Use a medium and workflow that targets Gram-negative enterics directly.
How do I troubleshoot if my MSA does not inhibit the E. coli negative control?
Recipe deviations can directly change selectivity. Common QC failures include incorrect NaCl concentration during preparation, using the wrong formulation, or improper melting or mixing that leads to uneven salt distribution. If controls do not behave as expected, do not interpret unknown samples.
If E. coli grows well around 37°C, why doesn’t it grow on MSA at that temperature?
E. coli’s usual growth failure on MSA is due to salt intolerance, not because the incubation temperature is wrong. The temperature used for MSA (around 35 to 37°C) matches E. coli’s optimal range, so if E. coli is inhibited, the selective agent is doing its job.
Could using a different manufacturer’s MSA, or a modified recipe, allow E. coli to grow?
Yes, if you use a different MSA formulation or a non-standard salt concentration, the outcome can change. The standard inhibitory effect relies on the designed NaCl level, so any variation in medium strength or indicator chemistry can reduce selectivity. Confirm you are using the correct, labeled MSA product and preparation instructions.
What would make my “no growth” result on MSA trustworthy versus misleading?
If your plate shows no growth where you expected E. coli, that is the correct outcome under standard conditions. If you also see that your positive control (staphylococci) grows with the expected yellow zone behavior and your negative control (E. coli) remains inhibited, then your unknown result is reliable.
Can Bacteria Grow in Vinegar? pH, Survival, and Safety Tips
Explore if bacteria can grow in vinegar, how pH and dilution affect survival, and practical food-safety storage tips.

